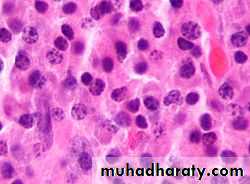

Multiple Myeloma
Malignant proliferation of plasma cells.• Normal plasma cell form immunoglobulin (Ig) which contain heavy and light chain
• Normal variety of Ig polyclonal & each contain Kappa & Lambda light chain
• Myeloma plasma cell : Ig of single heavy and light chain lead to monoclonal protein (para protein)
• In some light chain may be only produced and appear in urine as Bence-Jones proteinuria.
• Incidence : 4 new cases/100,000 peoples/year.
• Sex ratio : M:F → 2:1
• Age : median age 60-70 years.
• Etiology : Unknown
Classification of MM
• Paraprotein frequency %• IgG 55%
• IgA 21%
• Light chain only 22%
• Other (D, E, non secretory) 2%
• The diagnosis of MM requires two of the following :
marrow plasmacytosis.
Serum and/or urinary paraprotein
+
≥ 1 of `` CRAB``
Multiple Myeloma
• Symptoms• Effect
• Pathology
• Pain
• Severe local pain
• Lethergy,
• thirst
• Anaemia& tiredness
• Bone erosion due to stimulation of osteoclast.
• Pathological fracture
• Hypercalcaemia
• BM failure
• Marrow involvement with malignant plasma cell
• Renal damage
• Increased blood viscosity
• Amylidosis -renal damage
• Excess production of light chains and paraprotein
• Infection (Resp.)
• Impaired immune function
• Reduction in number of normal plasma cells
Clinical features
• Weight loss ,malaise and fatigue.
• Bone pain found in 60% of cases at the back and ribs.
• Anorexia , diarrhea, vomiting, constipation, polyuria, polydipsia occur with hypercalcemia in 30%,
• Renal impairment due to hypercalcaemia and dehydration present in 50% .
• Pneumococcal, chest and urinary tract infection due to low immunoglobulin(Ig) production.
• Headache , Confusion, Breathlessness, Visual Disturbance and bleeding can occur secondary to hyperviscosity (IgA).
• 5% present with paralysis secondary to spinal cord compression by extra-dural plasma cell mass.
• Carpal-tunnel syndrome, nephrotic syndrome, cardiac failure and neuropathy secondary to amyloid deposition.
• Absence of immunoparaesis should cast doubt on diagnosis.
• Only about 5% of pts with ESR persistently above 100 mm in the 1st hour have meyeloma.Management
**Immediate support• High fluid intake to treat renal impairment and hypercalcaemia
• Analgesia for bone pain.
• Bisphosphonates for hypercalcaemia and to delay other skeletal related events .
• Allopurinol to prevent urate nephropathy.
• Plasmapheresis, if necessary, for hyperviscosity
**Chemotherapy with or without HSCT
In older patients, thalidomide combined with the alkylating agent melphalan and prednisolone (MPT) has increased the median overall survival to more than 4 years.
• In younger, fitter patients, standard treatment includes first-line chemotherapy such as cyclophosphamide, thalidomide and dexamethasone (CTD) or bortezomib (Velcade), thalidomide and dexamethasone (VTD) to maximum response and then an autologous HSCT
Cont.-Management
1-BORTEZOMIB(VELCADE) VTD+Z2- Thalidomide
3-Lenalidomide(Revlimid) VRD+Z
4- Dexamethasone
5-Bisphosphonate (Zoledronate) reduces bone pain and skeletal events.
These rugs protect bone and may cause apoptosis of malignant plasma cells.
Osteonecrosis of the jaw may be associated with long-term use or poor oral hygiene and gum sepsis
Treatment is administered until paraprotein levels have stopped falling. This is termed ‘plateau phase’ and can last for weeks or years
In all patients who have achieved maximal response, lenalidomide maintenance has been shown to prolonge the response.
A second-generation proteasome inhibitor, carfilzomib, and the anti-CD38 antibody daratumumab show promise in relapsed/ refractory disease. Responding patients
may benefit from a second autologous HSCT
Radiotherapy; for localised bone pain and for pathological fractures.
It is also useful for the emergency treatment of spinal cord compression complicating extradural plasmacytomas** CAR-T CELL THERAPY
Prognosis
The international staging system (ISS) identifies poor prognostic features, including a high β2-microglobulin and low albumin at diagnosis (ISS stage 3, median survival 29 months).Those with a normal albumin and a low β2-microglobulin (ISS stage 1) have a median survival of 62 months.
Cytogenetic analysis is used to identify poor-risk patients, e.g. t(4;14), del(17/17p), t(14;16), t(14;20).
Over one-third of patients are now surviving for 5 years, compared with only one-quarter 10 years ago.
Waldenstrӧm macroglobulinaemia
This is a low-grade lymphoplasmacytoid lymphoma associated with an IgM paraprotein.Patients classically present with features of hyperviscosity,such as nosebleeds, bruising, confusion and visual disturbance.
Anaemia,systemic symptoms,splenomegaly or lymphadenopathy
Investigation; IgM paraprotein by immunofixation electrophoresis associated with a raised plasma viscosity.The bone marrow with infiltration of lymphoid cells and prominent mast cells.
TREATMENT
1- Plasmapheresis for anaemia and hyperviscosity.2- Chlorambucil
3- Fludarabine
4- Rituximab alone can cause a rapid release of IgM and increase in viscosity
5-Ibrutinib is very effective and has recently been licensed for use.
*Monoclonal gammopathy of uncertain significance (MGUS);
a paraprotein is present in the blood but with no other features of myeloma, Waldenstrӧm macroglobulinaemia, lymphoma or related disease.
The bone marrow may have increased plasma cells but these usually constitute less than 10% of nucleated cells.
After follow-up of 20 years, only one-quarter of cases will progress to myeloma or a related disorder (i.e.around 1% per annum)